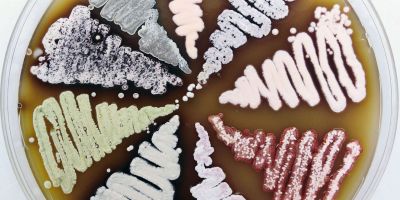

Eко-биотехнологијa и развој лекова
-
Наша група се бави бројним темама на додиру биологије и хемије.
Развијамо еколошке и одрживе процесе засноване на микроорганизмима и њиховим ензимима. Користимо биолошки активне метаболите микроорганизама као полазне тачке за њихову даљу структурну оптимизацију и унапређење активности. Занимају нас механизми еволутивних процеса који обликују микробиолошки метаболизам (биосинтетски путеви, протеини, биополимери и биолошки активни секундарни метаболити), као и динамика комплексних микробних заједница.
Примена нашег истраживања обухвата биотехнолошка решења, од употребе микроорганизама за рециклирање пластичног отпада у молекуле са додатном вредношћу, до развоја нових метода за борбу против патогена отпорних на антибиотике. Такође, истражујемо функционалне биоматеријале за биомедицинске, еколошке и каталитичке примене, укључујући паметне биополимерне структуре, антимикробне текстиле и системе за испоруку биолошки активних једињења. Наш рад за циљ има да интегрише ензимски инжењеринг, дизајн микробних конзорцијума и одрживу биотехнологију у циљу решавања изазова циркуларне биоекономије и зелене хемије.
- Проблеми пластике и други еколошки проблеми кроз биокатализу и синтетичку биологију
- „Све што је БИО“ - биоматеријали, биофилмови, биосензори, биопигменти, биосурфактанти, биоремедијација, биоекономија…
- Истраживања ка следећој генерацији еколошких, зеленијих и јефтиних биофармацеутика
- Биоактивни материјали за здравље и одрживост
- Биотехнолошки релевантни ензими и диригована еволуција
-

Јасмина Никодиновић-Рунић
научни саветникEко-биотехнологијa и развој лекова
Департман за микробиологију и биологију биљакаДр Јасмина Никодиновић-Рунић је научни саветник на Институту за молекуларну генетику и генетичко инжењерство Универзитета у Београду, где руководи Групом за еко-биотехнологију и развој лекова која је посвећена развоју одрживих биотехнолошких решења за глобалне проблеме као што су загађење животне средине пластичним отпадом и све већи број резистентних микроорганизама, изазивача болести. Докторирала је на Универзитету у Новом Јужном Велсу (Сиднеј, Аустралија) на биосинтези амфотерицина Б, антифунгалног природног производа из стрептомицете, а након постдокторских ангажмана у Сједињеним Америчким Државама и Ирској, свој научни и академски пут наставила је у Србији.
У фокусу њеног истраживачког рада су иновативни приступи у области биокатализе, биоактивних бактеријских метаболита и функционализације бактеријских биополимера, попут бактеријске наноцелулозе и полихидроксиалканоата, као и развој процеса претварања пластичног отпада у вредне биопигменте и биополимере.
Кроз бројне домаће и међународне пројекте, укључујући H2020, HE и EIC Pathfinder иницијативе, др Никодиновић-Рунић доприноси креирању циркуларне биоекономије и развоју еколошки прихватљивих технологија. Њени научни доприноси обухватају развој и примену ефикасних биокатализатора, примену бактеријских продуката у борби против гљивичних и туморских обољења, као и унапређење методологија у синтези биополимера. Једна је од аутора на четири међународна патента у области биотехнологије, а као ментор више од двадесет докторских дисертација, како у Србији тако и у иностранству, значајно доприноси развоју нове генерације истраживача. Активна је чланица више европских и светских стручних удружења и учествује у раду уредничких одбора релевантних научних часописа, што потврђује њену међународну препознатљивост у области примењене микробиологије и биокатализе.
Поред истраживачког рада, интензивно је укључена у промоцију науке кроз академске и јавне канале. Посебно се залаже за повезивање академске заједнице са индустријом кроз иновационе пројекте, као и за оснаживање интердисциплинарних сарадњи науке и уметности.
-
НАУЧНИ САВЕТНИК
ВИШИ НАУЧНИ САРАДНИЦИ
НАУЧНИ САРАДНИЦИ
ИСТРАЖИВАЧИ САРАДНИЦИ
ИСТРАЖИВАЧИ ПРИПРАВНИЦИ
СТРУЧНИ САРАДНИЦИ
-
Кључне публикације
- Nenadovic M, Ponjavic M, Pantelic B, Guzik M, Majka TM, Sourkouni G, Maršavelski A, Nikodinovic-Runic J. Efficient degradation of consumer-grade PLA by commercial Savinase: optimized conditions and molecular dynamics insights. ACS Sustain Chem Eng 2025;13(24):9269. doi: 10.1021/acssuschemeng.5c02063
- Filipovic V, Nikodinovic-Runic J, Savikin K, Zivkovic J, Mudric J, Krgovic N, Ponjavic M. Bacterial nanocellulose and its oxidized form as functional carriers for pomegranate peel extract: a sustainable approach to bioactive delivery. Future Foods. 2025;11:100560. doi: 10.1016/j.fufo.2025.100560
- Skaro Bogojevic S, Krstić Đ, Filipovic V, Pantelic L, Nikodinovic-Runic J, Trifković J, Vojnovic S, Simic J. Organic and natural deep eutectic solvents for the extraction of bacterial prodiginine biopigments. J Mol Liq. 2025;434:128063. doi: 10.1016/j.molliq.2024.128063
- Nenadovic M, Maršavelski A, Škaro Bogojević S, Maslak V, Nikodinović-Runić J, Milovanović J. New model compounds for the efficient colorimetric screening of medium chain length polyhydroxyalkanoate (mcl-PHA) depolymerases reveal mechanism of activity. Int J Biol Macromol. 2024;283(Pt 3):137672. doi: 10.1016/j.ijbiomac.2024.137672
- Malagurski I, Lazic J, Ilić-Tomic T, Salevic A, Guzik M, Krzan M, Nikodinovic-Runic J, Ponjavic M. Double layer bacterial nanocellulose–poly(hydroxyoctanoate) film activated by prodigiosin as sustainable, transparent, UV-blocking material. Int J Biol Macromol. 2024;279(Pt 1):135087. doi: 10.1016/j.ijbiomac.2024.135087